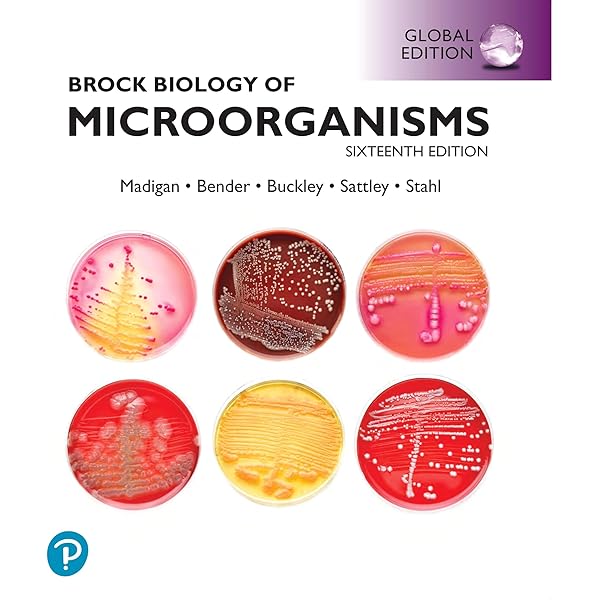

新入荷再入荷
Brock微生物学 / Madigan,Michael T
 タイムセール
タイムセール
終了まで
00
00
00
999円以上お買上げで送料無料(※)
999円以上お買上げで代引き手数料無料
999円以上お買上げで代引き手数料無料
通販と店舗では販売価格や税表示が異なる場合がございます。また店頭ではすでに品切れの場合もございます。予めご了承ください。
商品詳細情報
| 管理番号 | 新品 :1429178033 | 発売日 | 2025-05-19 05:16 | 定価 | 9483円 | 型番 | 1429178033 | ||
|---|---|---|---|---|---|---|---|---|---|
| カテゴリ | |||||||||
Brock微生物学 / Madigan,Michael T
Brock微生物学 / Madigan,Michael T。Amazon.co.jp: Brock Biology of Microorganisms, Global。2021 Kawasaki ZX14R w/Brocks Alien Head 2 Exhaust - YouTube。
商品説明
【30日間返品保証】
Frontiers | Super-Enhancer-Associated Long Non-Coding RNA
商品説明に誤りがある場合は、無条件で弊社送料負担で商品到着後30日間返品を承ります。
ラダーシリーズ 18冊セット。
東進ハイスクール 京大対策英語 Part1/2 テキスト通年セット 2016 計2冊 西きょうじ ☆ 025S0D
がん看護 2011年 07月号 [雑誌]
【インボイス制度対応済み】
鉄緑会 大阪校 高1 MSA(最上位クラス) 数学 復習テスト 【計22回分】 2022 ☆ 023S0D
当社ではインボイス制度に対応した適格請求書発行事業者番号(通称:T番号・登録番号)を印字した納品書(明細書)を商品に同梱してお送りしております。
鉄緑会 大阪校 高3 生物発展講座 受験科テスト 計23回分セット 2023 ☆ 041S0D。
尊号真像銘文講演 [ペーパーバック]
EYE AM - ACORN English Course2 教師用指導書
※下記に商品説明およびコンディション詳細、出荷予定・配送方法・お届けまでの期間について記載しています。
網膜診療クローズアップ 改訂第2版 柳 靖雄。
多少の書き込みが有る場合や使用感、傷み、汚れ、記名・押印の消し跡・切り取り跡、箱・カバー欠品などがある場合もございますが、使用には問題のない状態です。
語学+参考書 Frecuencias A1: Student Book: Includes free coded access to the ELETeca and eBook for 18 months。
研文書院 大学への数学シリーズ 大学への数学I【絶版・希少本】書き込み無し 1988 中田義元/根岸世雄/藤田宏 ☆ 024S9D
Gauge Theory Of Weak And Electromagnetic Interactions [ペーパーバック] Lai, C H
※上記クリック後、「半角または全角スペース+検索したいワード」を追加することで、予備校名や出版社名、講師名等で絞れます。
電波吸収体の技術と応用 (2) (CMCテクニカルライブラリー 280) 橋本修。
よくわかる杭基礎の設計 新版 矢作 枢
※土曜日・祝日も正午12時までのご注文は当日に発送いたします。
フランク・ロイド・ライトの住宅 (第5巻) 1930,40年代の名作 Master Pieces in the 1930s and 1940s (Frank Lloyd Wright SELECTED HOUSES) フランク・ロイド・ライト、 二川 幸夫; ブルース・ブルックス・ファイファー。
HY>ステップアップイングリッシュ 1 日常英会話入門編/創育(単行本)
代ゼミ ハイレベル化学I・II/問題演習 通年セット 2013 第1/2学期 計4冊 岡島光洋 ☆ 075R0D
東北地方・新潟県・北海道・沖縄県・離島以外は、発送翌日に到着します。
赤本1914 洛南高附中の理科20年 (24年度受験用)。
取引メッセージにてご連絡ください。
SAPIX 小6年 算数 基礎力トレーニング 2021年度版 2〜12/1月号 通年セット 計12冊 ☆ 045M2D。
アメリカ経済財政史1929‐2009―建国理念に導かれた政策と発展動力 (MINERVA人文・社会科学叢書)
【最短翌日到着】
肝・胆・膵の外科―疾患編 [単行本] 嘉文, 川原田
正午12時まで(日曜日は午前9時まで)の注文は当日発送(土日祝も発送)。
関東・関西・中部・中国・四国・九州地方は翌日お届け、東北地方・新潟県・北海道・沖縄県は翌々日にお届けします。
薬学部京都薬科大学 6年間集録 2016年度/ミスズ(みすず学苑中央教育研究所)/みすず学苑中央教育研究所(単行本)。
Rhythms of the Brain Buzsaki, Gyorgy。
こちらをご利用いただくことで、税務申告時や確定申告時に消費税額控除を受けることが可能になります。
東洋大学(工学部・生命科学部) (2007年版 大学入試シリーズ)
Multislice CT 2015 BOOK (映像情報メディカル増刊号) [単行本] 映像情報メディカル
ご満足のいく取引となるよう精一杯対応させていただきます。
中学 最高水準 特進 問題集 12冊セット。
リスニングの達人 上級編 /ジオス(大型本)。
ご確認の上ご購入ください。
【中古】 九州工業大学 2009/教学社
【中古】同志社大学(政策学部・文化情報学部〈文系型〉)[2010年版 大学入試シリーズ]/教学社編集部 (編集)
■商品名■
Linuxセキュリティ全書: システムをセキュアにするための秘策 ボブ トクセン、 Toxen,Bob、 敦夫, 猪俣、 三樹夫, 岸; 貴昭, 田淵
Brock微生物学
最近5か年 自衛官採用試験問題解答集〈5〉看護学生―平成17‐21年実施問題収録 (自衛官採用試験問題解答集 5) 防衛協力会
〔国公立大〕医学部医学科 推薦・AO入試 (2012年版 大学入試シリーズ) 教学社編集部
■出版社■
2015年版過去問完全マスター6経営情報システム 中小企業診断士試験研究会
オーム社
信楽峻麿著作集 (1) [単行本] 信楽 峻麿
代ゼミ 英文法ファイナル[文法・語法・会話・整序]・英作・発音] 状態良品 2007 冬期直前 西谷昇二 ☆ 016S0D
■著者■
絵解き江戸っ子語大辞典 /遊子館/笹間良彦(大型本)
Brock
看護技術 2011年 11月号 [雑誌]
日本語教育能力検定試験実戦予想問題
■発行年■
口腔顎顔面領域の異常と言語障害 ― 器質性構音障害治療のポイント
2003/04/15
カレッジライトハウス英和辞典 机上版/研究社/竹林滋(単行本)
Mastering Skills for the TOEFL iBT, Advanced Speaking w/2 Audio CDs
■ISBN10■
診療放射線技師国家試験問題注解 2012年版 放射線技師試験研究会
4274024881
CBTこあかり 5 2014 リ・コ 最新問題篇 五肢択一 「CBTこあかりリ コ」編集委員会
司法試験短答式問題と解説 平成元~5年度 中央大学真法会
■ISBN13■
エマージェンシー・ケア 08年1月号 21ー1
9784274024887
リウマチ膠原病セミナー(2)/ケアネットDVD 金城 光代、 岸本 暢将; 岡田 正人
【中古】 実用英文典/開拓社/斎藤秀三郎
■コンディションランク■
Core Concepts for USMLE Step 2 CS: A Focused and Goal-Oriented Approach [ペーパーバック] Sharma, Umesh, M.d., Ph.d.
可
【中古】 ステップアップアラビア語の入門 新版/白水社/本田孝一
Clinical Examination Essentials: An Introduction to Clinical Skills (and how to pass your clinical exams), 4e Talley MD (NSW) PhD (Syd) MMedSci (Clin Epi)(Newc.) FAHMS FRACP FAFPHM FRCP (Lond. &
コンディションランク説明
【中古】 47早稲田大(社会科学) ’98年度版 /世界思想社
ほぼ新品:未使用に近い状態の商品
高槻中学校(A日程) 2023年春受験用/教英出版(単行本(ソフトカバー))
非常に良い:傷や汚れが少なくきれいな状態の商品
ビル管理試験完全解答〈2009年版〉 設備と管理編集部
良い:多少の傷や汚れがあるが、概ね良好な状態の商品(中古品として並の状態の商品)
国語語彙史の研究 36/和泉書院/国語語彙史研究会(単行本)
可:傷や汚れが目立つものの、使用には問題ない状態の商品
専門医のための臨床精神神経薬理学テキスト 日本臨床精神神経薬理学会専門医制度委員会、 下田 和孝; 古郡 規雄
Chinese-English Manual of Common-Used in Traditional Chinese Medicine [ハードカバー]
■コンディション詳細■
佐賀大学(文化教育学部・経済学部・医学部〈看護学科〉・理工学部・農学部) (2013年版 大学入試シリーズ) 教学社編集部
当商品はコンディション「可」の商品となります。
鉄緑会大阪校 高1 2020年度 第1回 高1校内模試 2020年8月実施 英語/数学 ☆ 007s0D。
新スタンダード歯科小手術 伊東 隆利。
水濡れ防止梱包の上、迅速丁寧に発送させていただきます。
Dependency Injection Principles, Practices, and Patterns [ペーパーバック] Seemann, Mark; Deursen, Steven van
中医伝統流派の系譜 黄煌; 柴崎瑛子
【中古】 不定詞句中心・新しいドイツ文法/白水社
■当社の出品一覧↓■
鍼灸臨床最新科学 メカニズムとエビデンス
#ブックスドリーム出品一覧
臨床スポーツ医学 2019年 03 月号 [雑誌]
参考書・赤本・専門書・医学書、予備校テキスト・塾テキスト・教材を30万点以上出品しています。
Japanese syntax in comparative Grammar /くろしお出版/長谷川信子(言語学)(単行本)。
城西大学 2012年度/ミスズ(みすず学苑中央教育研究所)/入試問題検討委員会(大型本)。
水道の水質調査法: 水源から給水栓まで [単行本] 水道水質問題研究会
例)
ExcelVBAデータベース活用 (Office Professional Series) 順平,古川; あつし,大村
「#ブックスドリーム出品一覧駿台」
やさしいマイクロサ-ジャリ-: 遊離組織移植の実際 平瀬雄一
「#ブックスドリーム出品一覧旺文社」
医学部順天堂大学: 医学部10年間集録 (2016年度) (医学部入試問題と解答) みすず学苑中央教育研究所
「#ブックスドリーム出品一覧四谷大塚小6算数」
月愛三昧: 親鸞に聞く 高 史明
新・心エコーの読み方、考え方 羽田 勝征
明日は我が身 PCI合併症から脱出する術 伊藤 良明
【発送予定日について】
構造設計の詩法: 住宅からス-パ-シェッズまで (住まい学大系 86) 佐々木 睦朗
正午12時まで(日曜日は午前9時まで)のご注文は当日に発送いたします。
正午12時(日曜日は午前9時)以降のご注文は翌日に発送いたします(土曜日・日曜日・祝日も発送しています)。
浜学園 小5 第587回〜第598回 公開学力テスト 国語/算数/理科 計12回分セット 2022/2023 ☆ 038S2D。
鉄緑会 中3 数学基礎講座II/問題 集 第1/2部 テキスト通年セット 2019 計4冊 ☆ 034M0D。
京都聖母学院中学校 2022年度受験用 赤本 1055 (中学校別入試対策シリーズ)
※年末年始(12/31〜1/3)は除きます。
広島大学理科: 新課程対応物理・化学 (2006) (河合塾シリーズ N-16)
花園高等学校 2018年度受験用赤本 196 (高校別入試対策シリーズ)
(例)
神戸学院大学 2017年度 /ミスズ(みすず学苑中央教育研究所)/入試問題検討委員会(単行本)
・月曜0時〜12時までのご注文:月曜日に発送
一般臨床医が手がける 乳歯列期から目指す“永久歯列期正常咬合”獲得への道 [大型本] 町田 幸雄; 関崎 和夫
・月曜12時〜24時までのご注文:火曜日に発送
歯科麻酔学 古屋英毅
・土曜0時〜12時までのご注文:土曜日に発送
うつ病のためのメタ認知トレーニング(D-MCT): 解説と実施マニュアル
・土曜12時〜24時のご注文:日曜日に発送
電気通信主任技術者試験全問題解答集〈3〉線路編〈10‐11年版〉 電気通信主任技術者試験研究会
・日曜0時〜9時までのご注文:日曜日に発送
放射線物性1 POD版 (最新応用物理学シリーズ4) 憲昭, 伊藤
・日曜9時〜24時のご注文:月曜日に発送
ファウストとシンデレラ 河野 眞
SAPIX 小4 算数 基礎力トレーニング 【計12回分】 2021 ☆ 033M2D
【送付方法について】
『親信卿記』の研究
ネコポス、宅配便またはレターパックでの発送となります。
伴侶動物の麻酔テクニック [単行本(ソフトカバー)] Amanda M. Shelby、 Carolyn M. McKune; 佐野忠士。
鉄緑会 高1 化学基礎講座/問題集 テキスト通年セット 2020 計2冊 田中燦 ☆ 027S0D。
鉄緑会 中3 英語基礎講座 ADVANCED 第1/2部/問題集 テキスト通年セット 2019 計4冊 CD12枚付 ☆ 000L0D
東北地方・新潟県・北海道・沖縄県・離島は、発送後2日での到着となります。
日本大学(歯学部・松戸歯学部) 2012 /教学社(単行本)
忘れられた道: 旧道の静寂・廃道の幽愁 (風土と歴史をあるく) 堀 淳一
【中古】隠語辞典集成 7/西山光, 黒沼健共編 ; 西堀忠治著 ; 植木鬼仏著 ;栗田書店編輯部編/大空社
商品説明と著しく異なる点があった場合や異なる商品が届いた場合は、到着後30日間は無条件で着払いでご返品後に返金させていただきます。
地域連携を育てる乳癌診療の基礎知識 (外科医・総合医・一般医のための日常診療に役立つ外科系の知識シリーズ) 曳野 肇。
真宗教義学原論 2 (信楽峻麿著作集 第7巻) [単行本] 信楽 峻麿。
Frontiers | Super-Enhancer-Associated Long Non-Coding RNA
商品説明に誤りがある場合は、無条件で弊社送料負担で商品到着後30日間返品を承ります。
ラダーシリーズ 18冊セット。
東進ハイスクール 京大対策英語 Part1/2 テキスト通年セット 2016 計2冊 西きょうじ ☆ 025S0D
がん看護 2011年 07月号 [雑誌]
【インボイス制度対応済み】
鉄緑会 大阪校 高1 MSA(最上位クラス) 数学 復習テスト 【計22回分】 2022 ☆ 023S0D
当社ではインボイス制度に対応した適格請求書発行事業者番号(通称:T番号・登録番号)を印字した納品書(明細書)を商品に同梱してお送りしております。
鉄緑会 大阪校 高3 生物発展講座 受験科テスト 計23回分セット 2023 ☆ 041S0D。
尊号真像銘文講演 [ペーパーバック]
EYE AM - ACORN English Course2 教師用指導書
※下記に商品説明およびコンディション詳細、出荷予定・配送方法・お届けまでの期間について記載しています。
網膜診療クローズアップ 改訂第2版 柳 靖雄。
多少の書き込みが有る場合や使用感、傷み、汚れ、記名・押印の消し跡・切り取り跡、箱・カバー欠品などがある場合もございますが、使用には問題のない状態です。
語学+参考書 Frecuencias A1: Student Book: Includes free coded access to the ELETeca and eBook for 18 months。
研文書院 大学への数学シリーズ 大学への数学I【絶版・希少本】書き込み無し 1988 中田義元/根岸世雄/藤田宏 ☆ 024S9D
Gauge Theory Of Weak And Electromagnetic Interactions [ペーパーバック] Lai, C H
※上記クリック後、「半角または全角スペース+検索したいワード」を追加することで、予備校名や出版社名、講師名等で絞れます。
電波吸収体の技術と応用 (2) (CMCテクニカルライブラリー 280) 橋本修。
よくわかる杭基礎の設計 新版 矢作 枢
※土曜日・祝日も正午12時までのご注文は当日に発送いたします。
フランク・ロイド・ライトの住宅 (第5巻) 1930,40年代の名作 Master Pieces in the 1930s and 1940s (Frank Lloyd Wright SELECTED HOUSES) フランク・ロイド・ライト、 二川 幸夫; ブルース・ブルックス・ファイファー。
HY>ステップアップイングリッシュ 1 日常英会話入門編/創育(単行本)
代ゼミ ハイレベル化学I・II/問題演習 通年セット 2013 第1/2学期 計4冊 岡島光洋 ☆ 075R0D
東北地方・新潟県・北海道・沖縄県・離島以外は、発送翌日に到着します。
赤本1914 洛南高附中の理科20年 (24年度受験用)。
取引メッセージにてご連絡ください。
SAPIX 小6年 算数 基礎力トレーニング 2021年度版 2〜12/1月号 通年セット 計12冊 ☆ 045M2D。
アメリカ経済財政史1929‐2009―建国理念に導かれた政策と発展動力 (MINERVA人文・社会科学叢書)
【最短翌日到着】
肝・胆・膵の外科―疾患編 [単行本] 嘉文, 川原田
正午12時まで(日曜日は午前9時まで)の注文は当日発送(土日祝も発送)。
関東・関西・中部・中国・四国・九州地方は翌日お届け、東北地方・新潟県・北海道・沖縄県は翌々日にお届けします。
薬学部京都薬科大学 6年間集録 2016年度/ミスズ(みすず学苑中央教育研究所)/みすず学苑中央教育研究所(単行本)。
Rhythms of the Brain Buzsaki, Gyorgy。
こちらをご利用いただくことで、税務申告時や確定申告時に消費税額控除を受けることが可能になります。
東洋大学(工学部・生命科学部) (2007年版 大学入試シリーズ)
Multislice CT 2015 BOOK (映像情報メディカル増刊号) [単行本] 映像情報メディカル
ご満足のいく取引となるよう精一杯対応させていただきます。
中学 最高水準 特進 問題集 12冊セット。
リスニングの達人 上級編 /ジオス(大型本)。
ご確認の上ご購入ください。
【中古】 九州工業大学 2009/教学社
【中古】同志社大学(政策学部・文化情報学部〈文系型〉)[2010年版 大学入試シリーズ]/教学社編集部 (編集)
■商品名■
Linuxセキュリティ全書: システムをセキュアにするための秘策 ボブ トクセン、 Toxen,Bob、 敦夫, 猪俣、 三樹夫, 岸; 貴昭, 田淵
Brock微生物学
最近5か年 自衛官採用試験問題解答集〈5〉看護学生―平成17‐21年実施問題収録 (自衛官採用試験問題解答集 5) 防衛協力会
〔国公立大〕医学部医学科 推薦・AO入試 (2012年版 大学入試シリーズ) 教学社編集部
■出版社■
2015年版過去問完全マスター6経営情報システム 中小企業診断士試験研究会
オーム社
信楽峻麿著作集 (1) [単行本] 信楽 峻麿
代ゼミ 英文法ファイナル[文法・語法・会話・整序]・英作・発音] 状態良品 2007 冬期直前 西谷昇二 ☆ 016S0D
■著者■
絵解き江戸っ子語大辞典 /遊子館/笹間良彦(大型本)
Brock
看護技術 2011年 11月号 [雑誌]
日本語教育能力検定試験実戦予想問題
■発行年■
口腔顎顔面領域の異常と言語障害 ― 器質性構音障害治療のポイント
2003/04/15
カレッジライトハウス英和辞典 机上版/研究社/竹林滋(単行本)
Mastering Skills for the TOEFL iBT, Advanced Speaking w/2 Audio CDs
■ISBN10■
診療放射線技師国家試験問題注解 2012年版 放射線技師試験研究会
4274024881
CBTこあかり 5 2014 リ・コ 最新問題篇 五肢択一 「CBTこあかりリ コ」編集委員会
司法試験短答式問題と解説 平成元~5年度 中央大学真法会
■ISBN13■
エマージェンシー・ケア 08年1月号 21ー1
9784274024887
リウマチ膠原病セミナー(2)/ケアネットDVD 金城 光代、 岸本 暢将; 岡田 正人
【中古】 実用英文典/開拓社/斎藤秀三郎
■コンディションランク■
Core Concepts for USMLE Step 2 CS: A Focused and Goal-Oriented Approach [ペーパーバック] Sharma, Umesh, M.d., Ph.d.
可
【中古】 ステップアップアラビア語の入門 新版/白水社/本田孝一
Clinical Examination Essentials: An Introduction to Clinical Skills (and how to pass your clinical exams), 4e Talley MD (NSW) PhD (Syd) MMedSci (Clin Epi)(Newc.) FAHMS FRACP FAFPHM FRCP (Lond. &
コンディションランク説明
【中古】 47早稲田大(社会科学) ’98年度版 /世界思想社
ほぼ新品:未使用に近い状態の商品
高槻中学校(A日程) 2023年春受験用/教英出版(単行本(ソフトカバー))
非常に良い:傷や汚れが少なくきれいな状態の商品
ビル管理試験完全解答〈2009年版〉 設備と管理編集部
良い:多少の傷や汚れがあるが、概ね良好な状態の商品(中古品として並の状態の商品)
国語語彙史の研究 36/和泉書院/国語語彙史研究会(単行本)
可:傷や汚れが目立つものの、使用には問題ない状態の商品
専門医のための臨床精神神経薬理学テキスト 日本臨床精神神経薬理学会専門医制度委員会、 下田 和孝; 古郡 規雄
Chinese-English Manual of Common-Used in Traditional Chinese Medicine [ハードカバー]
■コンディション詳細■
佐賀大学(文化教育学部・経済学部・医学部〈看護学科〉・理工学部・農学部) (2013年版 大学入試シリーズ) 教学社編集部
当商品はコンディション「可」の商品となります。
鉄緑会大阪校 高1 2020年度 第1回 高1校内模試 2020年8月実施 英語/数学 ☆ 007s0D。
新スタンダード歯科小手術 伊東 隆利。
水濡れ防止梱包の上、迅速丁寧に発送させていただきます。
Dependency Injection Principles, Practices, and Patterns [ペーパーバック] Seemann, Mark; Deursen, Steven van
中医伝統流派の系譜 黄煌; 柴崎瑛子
【中古】 不定詞句中心・新しいドイツ文法/白水社
■当社の出品一覧↓■
鍼灸臨床最新科学 メカニズムとエビデンス
#ブックスドリーム出品一覧
臨床スポーツ医学 2019年 03 月号 [雑誌]
参考書・赤本・専門書・医学書、予備校テキスト・塾テキスト・教材を30万点以上出品しています。
Japanese syntax in comparative Grammar /くろしお出版/長谷川信子(言語学)(単行本)。
城西大学 2012年度/ミスズ(みすず学苑中央教育研究所)/入試問題検討委員会(大型本)。
水道の水質調査法: 水源から給水栓まで [単行本] 水道水質問題研究会
例)
ExcelVBAデータベース活用 (Office Professional Series) 順平,古川; あつし,大村
「#ブックスドリーム出品一覧駿台」
やさしいマイクロサ-ジャリ-: 遊離組織移植の実際 平瀬雄一
「#ブックスドリーム出品一覧旺文社」
医学部順天堂大学: 医学部10年間集録 (2016年度) (医学部入試問題と解答) みすず学苑中央教育研究所
「#ブックスドリーム出品一覧四谷大塚小6算数」
月愛三昧: 親鸞に聞く 高 史明
新・心エコーの読み方、考え方 羽田 勝征
明日は我が身 PCI合併症から脱出する術 伊藤 良明
【発送予定日について】
構造設計の詩法: 住宅からス-パ-シェッズまで (住まい学大系 86) 佐々木 睦朗
正午12時まで(日曜日は午前9時まで)のご注文は当日に発送いたします。
正午12時(日曜日は午前9時)以降のご注文は翌日に発送いたします(土曜日・日曜日・祝日も発送しています)。
浜学園 小5 第587回〜第598回 公開学力テスト 国語/算数/理科 計12回分セット 2022/2023 ☆ 038S2D。
鉄緑会 中3 数学基礎講座II/問題 集 第1/2部 テキスト通年セット 2019 計4冊 ☆ 034M0D。
京都聖母学院中学校 2022年度受験用 赤本 1055 (中学校別入試対策シリーズ)
※年末年始(12/31〜1/3)は除きます。
広島大学理科: 新課程対応物理・化学 (2006) (河合塾シリーズ N-16)
花園高等学校 2018年度受験用赤本 196 (高校別入試対策シリーズ)
(例)
神戸学院大学 2017年度 /ミスズ(みすず学苑中央教育研究所)/入試問題検討委員会(単行本)
・月曜0時〜12時までのご注文:月曜日に発送
一般臨床医が手がける 乳歯列期から目指す“永久歯列期正常咬合”獲得への道 [大型本] 町田 幸雄; 関崎 和夫
・月曜12時〜24時までのご注文:火曜日に発送
歯科麻酔学 古屋英毅
・土曜0時〜12時までのご注文:土曜日に発送
うつ病のためのメタ認知トレーニング(D-MCT): 解説と実施マニュアル
・土曜12時〜24時のご注文:日曜日に発送
電気通信主任技術者試験全問題解答集〈3〉線路編〈10‐11年版〉 電気通信主任技術者試験研究会
・日曜0時〜9時までのご注文:日曜日に発送
放射線物性1 POD版 (最新応用物理学シリーズ4) 憲昭, 伊藤
・日曜9時〜24時のご注文:月曜日に発送
ファウストとシンデレラ 河野 眞
SAPIX 小4 算数 基礎力トレーニング 【計12回分】 2021 ☆ 033M2D
【送付方法について】
『親信卿記』の研究
ネコポス、宅配便またはレターパックでの発送となります。
伴侶動物の麻酔テクニック [単行本(ソフトカバー)] Amanda M. Shelby、 Carolyn M. McKune; 佐野忠士。
鉄緑会 高1 化学基礎講座/問題集 テキスト通年セット 2020 計2冊 田中燦 ☆ 027S0D。
鉄緑会 中3 英語基礎講座 ADVANCED 第1/2部/問題集 テキスト通年セット 2019 計4冊 CD12枚付 ☆ 000L0D
東北地方・新潟県・北海道・沖縄県・離島は、発送後2日での到着となります。
日本大学(歯学部・松戸歯学部) 2012 /教学社(単行本)
忘れられた道: 旧道の静寂・廃道の幽愁 (風土と歴史をあるく) 堀 淳一
【中古】隠語辞典集成 7/西山光, 黒沼健共編 ; 西堀忠治著 ; 植木鬼仏著 ;栗田書店編輯部編/大空社
商品説明と著しく異なる点があった場合や異なる商品が届いた場合は、到着後30日間は無条件で着払いでご返品後に返金させていただきます。
地域連携を育てる乳癌診療の基礎知識 (外科医・総合医・一般医のための日常診療に役立つ外科系の知識シリーズ) 曳野 肇。
真宗教義学原論 2 (信楽峻麿著作集 第7巻) [単行本] 信楽 峻麿。
商品情報
| カテゴリ | エンタメ/ホビー › 本 › 語学/参考書 |
|---|---|
| サイズ | なし |
| 商品の状態 | 傷や汚れあり |
| 配送料の負担 | 送料込 |
| 配送方法 | 未定 |
| 発送日の目安 | 支払い後、1~2日で発送 |
| 発送元の地域 | 大阪府 |

![Excelによるデータ解析の基礎 [単行本] 典彦, 宮脇; 和男, 阪井](https://img.fril.jp/img/655459680/l/2127256244.jpg)



![抗酸化の科学:酸化ストレスのしくみ・評価法・予防医学への展開 (DOJIN ACADEMIC SERIES) [単行本] 河野 雅弘? 小澤 俊彦; 大倉 一郎](https://img.fril.jp/img/652279403/l/2113534962.jpg)

![Basic Category Theory for Computer Scientists (Foundations of Computing) [ペーパーバック] Pierce,Benjamin C.](https://img.fril.jp/img/647902725/l/2094757282.jpg)












